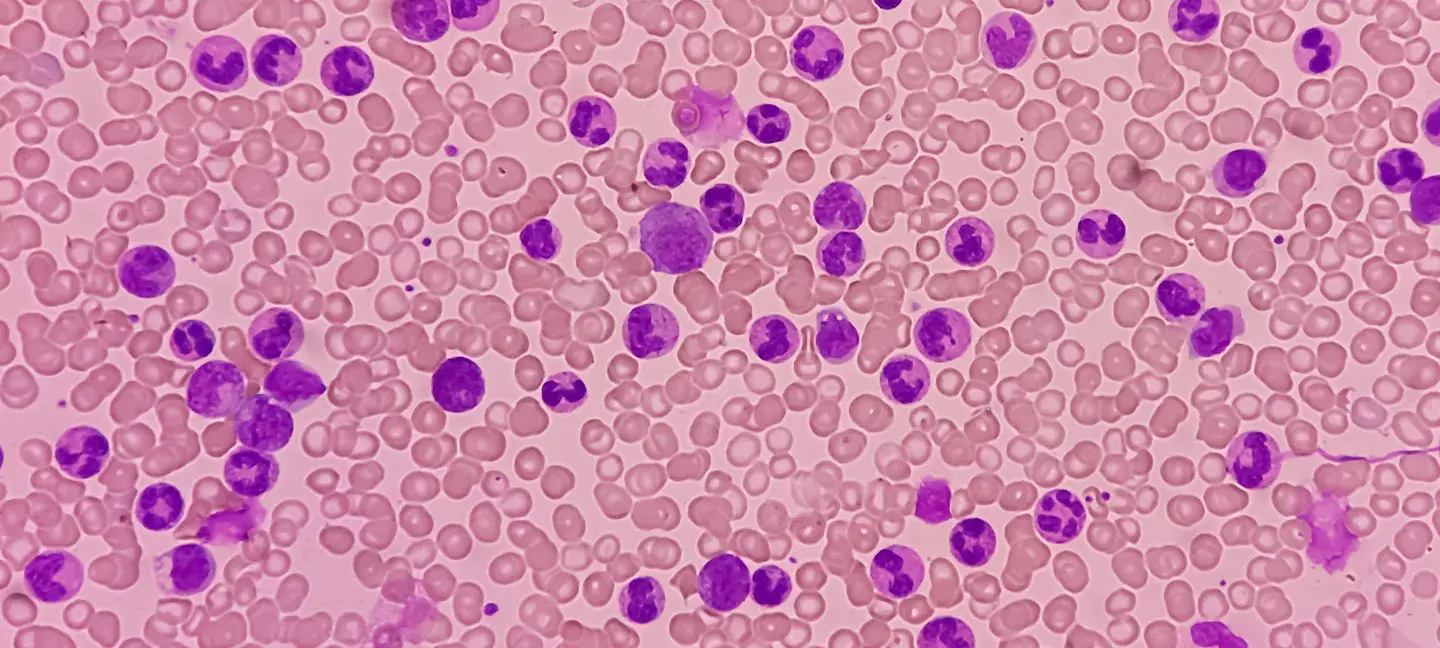
Leukemia

Toepassing
Waarvoor kun je deze subsidie gebruiken?
Deze regeling financiert nieuwe onderzoeksprojecten die naar verwachting impact hebben op leukemie en staat expliciet ook MDS-voorstellen toe. Het gaat om projecten onder leiding van een nieuwe investigator (early-career) met een onafhankelijke faculty-level positie en een eigen onderzoekslijn. De financiering is bedoeld voor inhoudelijke onderzoeksactiviteiten binnen het project (bijvoorbeeld personele inzet in het team, verbruiksgoederen en projectgerelateerde kosten), met duidelijke beperkingen op PI-salaris, overhead en grote apparatuur.
Welke projecten komen in aanmerking?
- Fundamenteel leukemieonderzoek
- Translationeel onderzoek
- Mechanistische studies
- Preklinische modellen
- Biomarkeronderzoek
- MDS-gerelateerd onderzoek
Werkgebied
Waar geldt deze subsidie?
- Internationaal (projecten van buiten de Verenigde Staten zijn toegestaan).
Voorwaarden
Welke voorwaarden gelden voor deze subsidie?
- Je bent een onafhankelijk onderzoeker verbonden aan een non-profit academische instelling bij start én gedurende de award.
- Je hebt bij indiening een onafhankelijke faculty-level positie (o.a. eigen labruimte, je werft/begeleidt labpersoneel en beslist over onderzoeksactiviteiten en besteding).
- Je valt binnen de definitie “new investigator” (≤ 7 jaar na eerste onafhankelijke faculty-aanstelling; resident/fellow/postdoc telt als training en niet mee).
- Loopbaanonderbrekingen kunnen worden meegewogen, mits je ze zelf benoemt en documenteert.
- Je dient maximaal één LOI in als Principal Investigator.
- Alle overige (relevante) projectondersteuning en mogelijke overlap in financiering moet je transparant vermelden.
Restricties
Waarvoor kun je géén subsidie aanvragen?
- Je bent niet eligible als je actieve grant(s) hebt met ≥ US$ 175.000 per jaar aan total direct costs (met uitzonderingen; zie hieronder).
- Fellows kunnen niet aanvragen.
- Niet eligible bij NIH R01, VA Merit Award of equivalent.
- Renewals worden niet geaccepteerd; eerdere ontvangers van een new investigator award van deze verstrekker kunnen niet opnieuw aanvragen.
- Co-PI’s zijn niet toegestaan.
- Bepaalde grants zijn wél toegestaan binnen de drempel: o.a. DOE/DOD/NSF, R21 of andere grants < US$ 175.000 per jaar direct costs; K08/R00/R99 tellen niet mee voor de US$ 175.000-drempel.
Subsidie
Hoeveel subsidie kun je aanvragen?
- Maximaal bedrag: US$ 150.000 totaal (2 jaar).
- Subsidiebudget/plafond: Geen informatie beschikbaar.
- Kapitaalapparatuur: geen financiering voor equipment-aankopen boven US$ 7.500, tenzij je een uitzondering onderbouwt met specifieke noodzaak voor het project.
- PI-salaris: niet toegestaan.
- Onderzoeksreizen: toegestaan tot maximaal US$ 3.000 en bedoeld ter versterking van de studie.
- Indirect costs/overhead: niet toegestaan.
Subsidieadvies
Wat zijn goede tips voor je subsidieaanvraag?
- Hoe laat je zien dat je ‘new investigator’ bent volgens de definitie?
Maak je tijdlijn vanaf je eerste onafhankelijke faculty-aanstelling expliciet en zet trainingjaren (resident/fellow/postdoc) apart, zodat je binnen de 7-jaarsregel aantoonbaar bent. - Hoe onderbouw je een loopbaanonderbreking zonder ruis in je eligibility?
Benoem de onderbreking concreet en lever documentatie aan; de beoordeling kan hiervoor worden aangepast, maar jij moet dit zelf aandragen. - Hoe voorkom je dat je op financieringsdrempels wordt afgewezen?
Maak een helder overzicht van alle actieve grants en total direct costs per jaar, en geef expliciet aan welke awards (zoals K08/R00/R99) buiten de US$ 175.000-drempel vallen. - Hoe bouw je een ‘allowable’ begroting?
Plan geen PI-salaris of overhead in, beperk research travel tot maximaal US$ 3.000, en motiveer eventuele apparatuurbehoefte zorgvuldig—zeker als die richting de US$ 7.500-grens gaat. - Wat is een praktische best practice voor dit type LOI→full aanvraag?
Schrijf je LOI alsof het een mini-projectplan is (doel, aanpak, verwachte impact, haalbaarheid in 2 jaar) en dien ruim vóór de deadline in om technische risico’s te vermijden.
Aanvragen
Hoe kun je deze subsidie aanvragen?
- Stap 1: Letter of Intent (LOI). Je dient een LOI digitaal in via het grants-managementsysteem (account vereist, zie links).
- Stap 2: Full application (alleen op uitnodiging). Na LOI-review ontvangen geselecteerde onderzoekers een e-mail met instructies en een link naar de volledige aanvraag.
Wanneer moet je wat indienen?
- LOI opent: 5 december 2025
- LOI deadline: 6 februari 2026, 12:00 CT
- Uitnodiging full application: 13 maart 2026
- Full application deadline: 13 april 2026, 12:00 CT
- Uitslag: uiterlijk 30 juni 2026
- Start funding cycle: 1 juli 2026